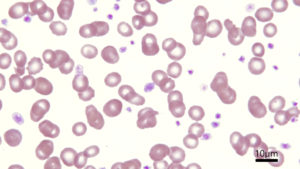

2025年 仕事納め
ただいま2025年12月31日の17時を過ぎたところです。本年もこのブログの更新をもって仕事納めとさせていただきます。新年は1月5日の月曜日から通常診療を再開予定です。その間で救急対応が必要と判断される場合、「横浜動物救急診療センターVECCS Yokohama」へ事前連絡の上、受診のご相談をよろしくお願い致します。
ちなみにこの仕事納めの記事を投稿して24時間以内に2年連続で珍事が発生しています。2024年の元旦の朝にはパン切り包丁で指をざっくり切り付け、2024年の大晦日の日には鍵を排水溝の中に落下させて一瞬家に帰れなくなるという。さすが前厄、本厄の年ですね。このあと2026年は後厄の年に該当するので、また何か24時間以内にイベントが生じなければ良いのですが。
とりあえず、今までずっと無料という契約で使えていたドメイン(このホームページのアドレスのことです)に対して、「来年からお金請求することにしたわ、異議を認めないよ☆」という趣旨のメールがこの年末に届きまして。詐欺か手違いメールかと思って問い合わせたら、ドメイン管理会社から本気メールですという回答を本日いただいて驚きを隠せないでおります。そんなジャブはすでにくらっておりますが、これ以上良い右ストレートがこのあときませんように。
昨日も残業で事務仕事をしていたら救急車などのサイレンの音が鳴り響いてましたし、買い出し客でにぎわう松原商店街の方からはおじさん同士がやんのかやんのかって言い合っている声が聞こえてきました。結局何もやらなかったのだろうと信じておりますが、やんのかステップは猫だけにして欲しいところですね。心がざわついてしまいます。そのような騒動に皆さまも巻き込まれませぬよう充分お気を付けください。人も動物も穏やかな年末年始がゆっくり過ごせるよう心からお祈りしております。それでは、来年もどうぞよろしくお願い申し上げます。